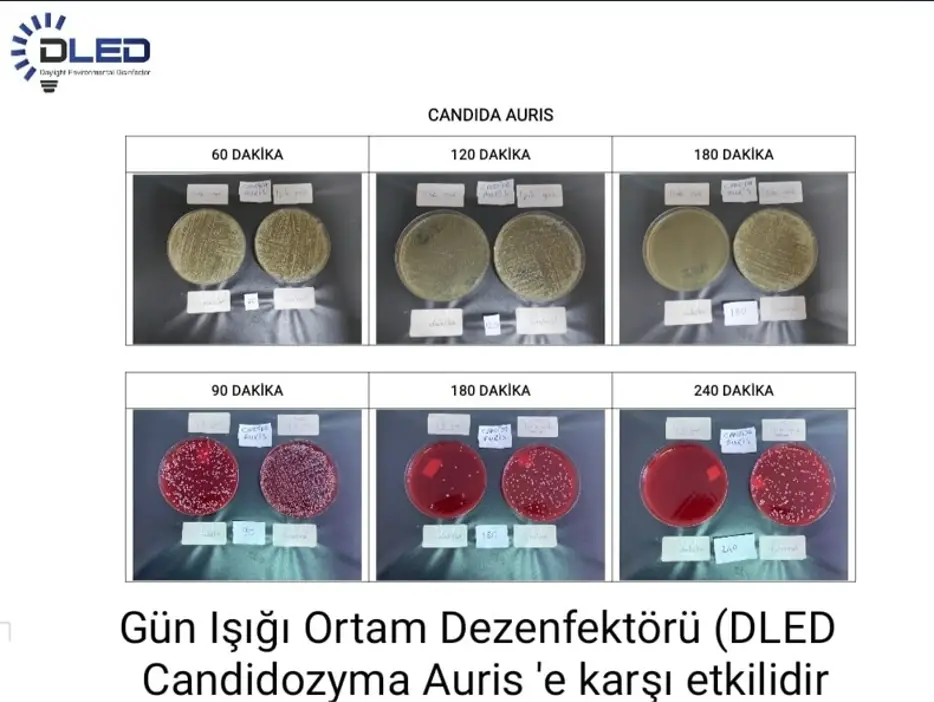
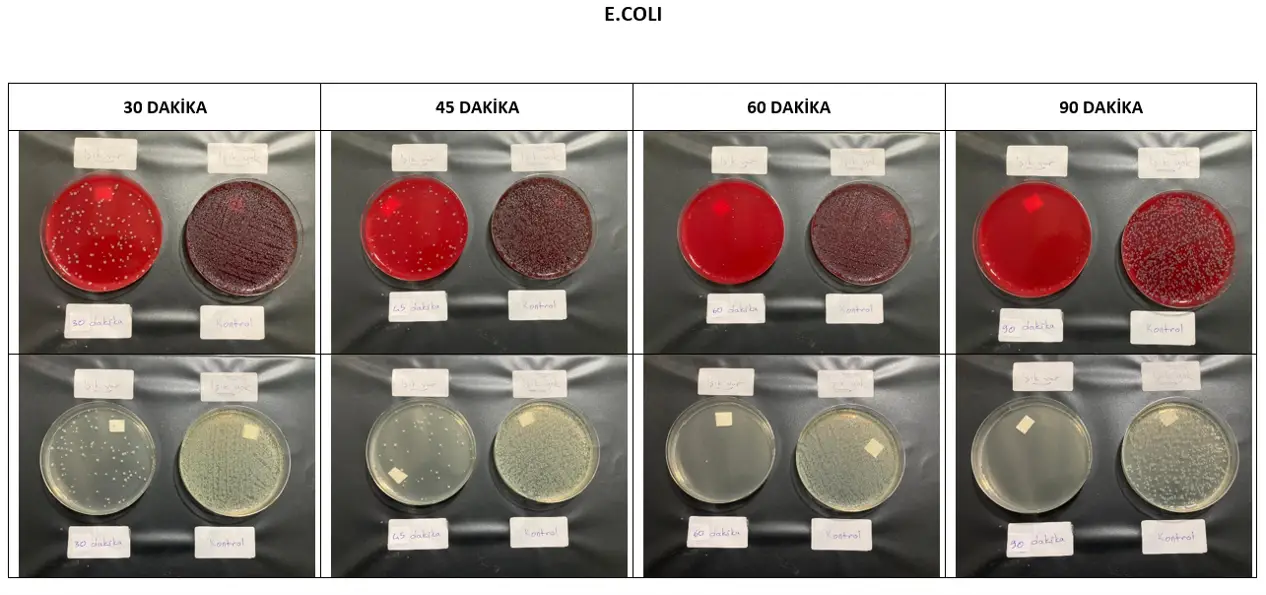
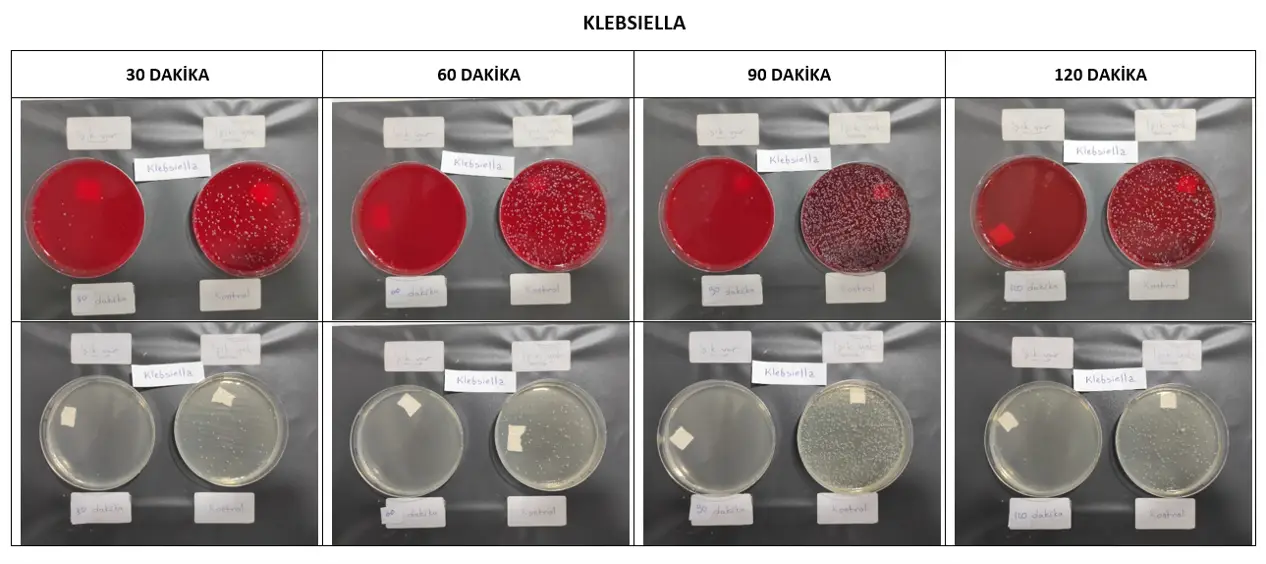
Gallery Title Here

Safe Disinfection with Daylight: DLED Technology
DLED (Daylight LED) is a detachable ambient disinfectant that operates at daylight wavelengths, offering an alternative to traditional disinfection methods. With the rise of the healthcare sector, this technology plays an effective role in combating serious problems, particularly in hospital systems, where there is a risk of disease. DLED is a modern take on the concept of sunlight-based treatment, traditionally used in military clinics.
What is DLED and how does it work?
DLED is an LED system that emits light in a spectrum similar to daylight, developed with nano-atomic conductors, special resistor systems, and frequency-regulating software support. Operating in the 430-680 nm range, this technology does not contain UV rays, therefore it poses no carcinogenic risk and does not emit ozone. This makes it both human health-friendly and environmentally conscious.
Its mechanism of action is based on photo-stimulating the intracellular molecules of microorganisms, creating oxidative stress. Thus, it exhibits a lethal effect on gram-negative and gram-positive bacteria, anaerobic and aerobic species, yeasts, and enveloped and non-enveloped viruses. This system, which provides continuous disinfection, minimizes airborne and surface contact contamination.
Proven Microbiological Efficacy
The effectiveness of DLED technology has also been supported by scientific analyses. Microbiological efficacy analyses provide reliable and rapid results on many pathogens, including biofilm-forming bacteria. In this respect, it can be used safely, especially in areas where the risk of contamination is high.
Areas of Use
DLED offers a wide range of applications:
Operating rooms
Intensive care units and emergency departments
Oncology and dialysis units
Burn treatment centers
Community living spaces and all other environments where hygiene is critical
Thanks to this system, the risk of spreading healthcare-associated infections is reduced, hospital stays are shortened, and the cost burden on the healthcare system is lowered.
Why DLED?
Combining the therapeutic power of sunlight with the possibilities of the digital age, DLED is a revolutionary solution for hospitals and public spaces. It offers a more sustainable, harmless, and consistently effective alternative to traditional cleaning and UV-based disinfection methods. Furthermore, its user-friendly design requires no additional application or training.
To learn more about DLED technology or to request custom solution recommendations for your project, please visit our contact page.
In addition, if you would like to receive technical consultancy regarding application areas, you can contact us here.
For any questions related to DLED, please reach out to our support team.
Features of DLED Technology